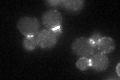
YCR030C
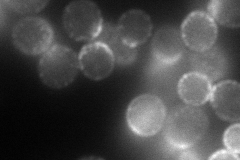
YCR030C
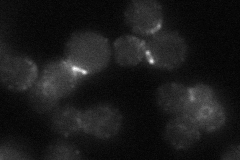
YCR030C
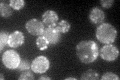
YCR030C

View description
Protein of unknown function that is involved in endocytic site formation; may regulate assembly and disassembly of the septin ring; colocalizes and interacts with septin subunits; potential role in actin cytoskeletal organization
Localization:
Intensity:
Fold change:
Significance:
-
C’ GFP library in SD
punctate, bud neck -
N' NOP1pr-GFP in SD
cell periphery,punctate,bud neck107.319 -
N' TEF2pr-mCherry in SD

missing0 -
N' NATIVEpr-GFP in SD
punctate,bud neck34.4162 -
N' TEF2pr-VC and Cyto-VN in SD

#N/A0 -
C’ GFP library in SD+DTT

punctate, bud neck61.521.61Yes -
C’ GFP library in SD+H2O2

punctate, bud neck46.441.22No -
C’ GFP library in Starvation Media
punctateN/AN/AYes -
C’ GFP library on the background of Pup2-DaMP

punctate, bud neck -
C’ GFP library on the background of CCT mutant

punctate, bud neck41.15981.08191No
